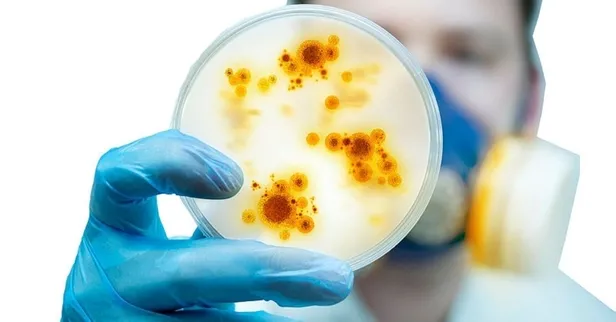

Meğer Koronavirüse böyle yakalanıyormuşuz! Yeni öğrenildi! Karaciğer, mide, bağırsaklardan sinir sistemine kadar...
Dünya genelinde 20 milyona yakın kişiye bulaşan yeni tip koronavirüs 600 bine yakın kişinin de hayatını kaybetmesine neden oldu. Vücudumuzu ele geçiren koronavirüs bağırsaklardan sinir sistemine kadar birçok organı etkiliyor. Sağlık Bakanlığı Toplum Bilimleri Kurulu Üyesi Prof. Dr. Mustafa Necmi İlhan, AA muhabirine yaptığı açıklamada, Çin'in Hubey eyaletine bağlı Vuhan kentinde Aralık 2019'da ortaya çıkan ve kısa sürede dünyaya yayılan Kovid-19'un etki gücünün hala son derece yüksek olduğunu, kısıtlama, karantina gibi tedbirlerin ardından normalleşme sürecinde de vakaların görüldüğünü vurguladı. Peki koronavirüse nasıl yakalanıyoruz? Bilim Kurulu Üyesi Prof. Dr. Mustafa Necmi İlhan tek tek anlattı.
Yeni tip Koronavirüs ile ilgili son dakika gelişmeleri yaşanmaya devam ediyor. Dünya genelinde yaklaşık 20 milyon kişiyi etkisi altına alan Koronavirüs hakkında bilinmeyenler ortaya çıktı. Yeni tip koronavirüsün (Kovid-19) bulaşma riski uzun seyahatlerde, insanların bir araya geldiği törenler ve ziyaretlerde, toplu yapılan etkinliklerde artıyor. Öksürme, aksırma, hapşırma ile havaya saçılan virüs, bulunduğu ortam veya eşyalara dokunulduktan sonra ağız ve buruna taşınıyor, solunum yolu, karaciğer, mide, bağırsak, sinir sistemine ulaşıyor ve hastalığa yol açıyor. Peki koronavirüse nasıl yakalanıyoruz? Bilim Kurulu Üyesi Prof. Dr. Mustafa Necmi İlhan tek tek anlattı.
Koronavirüse böyle yakalanıyoruz! Karaciğer, mide, bağırsaklardan sinir sistemine kadar...
Sağlık Bakanlığı Toplum Bilimleri Kurulu Üyesi Prof. Dr. Mustafa Necmi İlhan, AA muhabirine yaptığı açıklamada, Çin'in Hubey eyaletine bağlı Vuhan kentinde Aralık 2019'da ortaya çıkan ve kısa sürede dünyaya yayılan Kovid-19'un etki gücünün hala son derece yüksek olduğunu, kısıtlama, karantina gibi tedbirlerin ardından normalleşme sürecinde de vakaların görüldüğünü vurguladı.
Koronavirüslerin (CoV), soğuk algınlığından Orta Doğu Solunum Sendromu (MERS-CoV) ve Şiddetli Akut Solunum Sendromu (SARS-CoV) gibi daha ciddi hastalıklara kadar çeşitli hastalıklara neden olan büyük bir virüs ailesi oldunu anlatan İlhan, Kovid-19'un da ölümcül seyredebilen bir hastalık olduğunu anımsattı.
Söz konusu virüsün bilim için çok yeni olduğunu ve henüz tam bilinmediğini hatırlatan İlhan, Kovid-19'un insandan insana damlacık yoluyla bulaştığını söyledi.

İlhan, "Virüs, solunum yolundan öksürme, aksırma, hapşırma ile havaya saçılan virüslerin bulunduğu ortam veya eşyalara dokunulduktan sonra ağız ve buruna taşınır. Virüs alındıktan sonra solunum yolu, karaciğer, mide, bağırsak, sinir sistemine ulaşır ve hastalık yapar." dedi.
Virüsün, herkesi farklı etkilediğine dikkati çeken, enfekte kişilerin çoğunun hafif ila orta düzeyde bulgular geliştirdiğini ve hastaneye kaldırılmadan iyileştiğini dile getiren İlhan, hastalığın en yaygın belirtilerinin ateş, kuru öksürük, yorgunluk; daha seyrek olarak boğaz ağrısı, ishal, konjunktivit, baş ağrısı, tat alma veya koku duyusunun kaybı, ciltte döküntü ya da el veya ayak parmaklarında renk değişimi ve ciddi bulguların ise solunum güçlüğü veya nefes darlığı, göğüs ağrısı veya göğüste baskı, konuşma veya hareket kaybı şeklinde bulgular gösterdiğini anlattı.
Bulguların ciddi boyutlara ulaşması halinde, derhal tıbbi yardım alınması gerektiğini vurgulayan İlhan, hafif belirtiler gösteren ve başka bir sağlık sorunu olmayan kişilerin, tedavi sürecini evde geçirebildiğini ifade etti.
İlhan, "Virüsle enfekte olan kişiler ortalama 5-6 gün içinde semptomları göstermeye başlar. Bununla birlikte, bu süre 14 günü bulabilir." dedi.

"İLLER ARASI SEYAHATLER KORONAVİRÜSÜN BULAŞMASINA ZEMİN HAZIRLAMAKTADIR"
Normalleşme adımları hayata geçirilirken virüsün etki gücünün bittiği yanılgısıyla hareket edilmemesi gerektiğini, bunun, geri dönüşü olmayan sonuçlara yol açabileceğini belirten İlhan, bu süreçte yeni vakaların ihmallerden kaynaklandığının ortaya konulduğuna dikkati çekti.
İlhan, "İller arası seyahatler koronavirüsün bulaşmasına zemin hazırlamaktadır." uyarısında bulunarak mümkün olduğunca toplu bir araya gelinen uzun seyahatlerden kaçınılması, zorunluluk halinde ise maskenin yol boyunca çıkarılmaması, ellerin ağız, burun ve göze değmemesine özen gösterilmesi ve hijyenin sağlanması gerektiğini belirtti.
Necmi İlhan, "Koronavirüs mücadelesinde geldiğimiz aşamada yeni vakaların daha çok düğün, nişan, sünnet, asker uğurlama gibi toplu olarak bir arada bulunulan yerlerden kaynaklandığı belirlendi. Yapılan filyasyon çalışmalarında (sahada temaslı arama) aynı törene katılan, hatta aynı soy isme sahip bireyler daha fazla sayıda karşımıza çıktı." diye konuştu.

"PLAJLARDA FİZİKSEL MESAFE ÖNEMLİ VE MASKE TAKILMALI"
Tatil beldelerinde de ihmallerin de çok risk taşıdığını anımsatan İlhan, "plajda, denizde ya da havuzda virüs bulaşmaz" algısının yanlış olduğunun altını çizdi.
İlhan, "Görülüyor ki çoğu zaman plaj ve denizde fizik mesafeyi sağlamak mümkün olmamakta, daha da riskli olarak plajda vatandaşlar maske takmamaktadır. Oysa bu alanlar virüs için çok uygun ortam oluşturmaktadır. Türkiye'de farklı illerden gelen vatandaşlar, hatta gurbetçi vatandaşlarımız ile risk daha da artmaktadır. Bu nedenle, tatil beldelerinde plajda etraftakilerle aradaki mesafenin en az 1,5-2 metre olması, deniz ya da havuzda yakın yüzülmemesi, ortak alanların kullanımında hijyene dikkat edilmesi, ortak duş, kabin kullanımından kaçınılması önem taşımaktadır." ifadelerini kullandı.

"KIŞLIK ERZAK İÇİN HAZIRLIKLAR TOPLU OLARAK YAPILMAMALI"
Sonbaharın da yaklaşmasının riski artıracağına değinen Prof. Dr. İlhan, "Önümüzdeki süreci en az temasla, en az bulaşma geçirmek zorundayız. Zira ağustos ayı geliyor ve sonbahara, insanların işine, okuluna, büyük şehirlere dönmesine az zaman kaldı. Bu nedenle ne kadar düşük rakamlar ile sonbahara girilirse o kadar az zarar ile süreç atlatılacaktır." değerlendirmesinde bulundu.
Eylül ayı ile mevsimsel grip, zatürre gibi bu dönemde en sık görülen ve ölümcül sonuçlara yol açabilen solunum yolu hastalıklarının da görülme sıklığının artacağını vurgulayan İlhan, bağışıklık sisteminin güçlü olmasının önemine işaret etti.
Sonbaharla birlikte kışlık yiyecek için de hazırlıkların yapılmaya başlandığını, bunun için çok sayıda kişinin bir araya gelebildiğini anlatan İlhan, şöyle konuştu:
"Malum yaz aylarında Anadolu'da kadınlarımız bir araya gelip kış hazırlığı yapıyor, tarhana, yufka gibi çeşitli erzaklar hazırlıyor. Kurban Bayramı sonrası etlerin parçalanması ve hazırlanması için de bir araya geliniyor. Kışlık erzak için hazırlıklar toplu olarak yapılmamalı, herkes kendi evinde yapmaya çalışmalı, birliktelikten olabildiğince kaçınılmalı. Eğer yapılacaksa bile maske takılmalı ve fiziksel mesafe korunarak çalışılmalı."

"TAZİYELER, MÜMKÜNSE İLETİŞİM ARAÇLARI İLE VERİLMELİ"
Türk gelenek ve göreneklerinde acı tatlı günde bir araya gelinmesinin çok önem taşıdığından düğün, asker uğurlama, sünnet ve cenaze törenlerinde çok sayıda kişinin aynı ortamda yer alabildiğine dikkati çeken İlhan, bu süreçte bundan kaçınılmasının hayati öneme sahip olduğuna işaret etti.
Yeni vakalarda asker uğurlama ve taziye ziyaretlerinin etkisinin olduğunun verilerle ortaya konduğunu hatırlatan İlhan, bunların da iletişim araçları kullanılarak yapılmasının uygun olduğunu belirtti.
Bilim Kurulu Üyesi Prof. Dr. İlhan, sözlerini şöyle tamamladı:
"Cenazelerde, özellikle camilerde fiziki mesafe kuralına uyulduğunu görüyoruz ancak taziyelerde kimi zaman fizik mesafe ve maske kuralına uyulmuyor. Her ne kadar bizim değerlerimizde taziye vermek çok önemli olsa da mümkünse şu an için iletişim araçları ile taziye verilmeli ya da kısa süreli temas etmeden fizik mesafe ve maske ile taziye yapılmalı. Mutlaka yapılacaksa, ziyarete gelenler toplu olarak kabul edilmemeli, maske asla çıkarılmamalı ve diğer tedbirlere uyulmalı. Unutmayalım, yaşamak ve yaşatabilmek için fiziksel mesafe, maske ve hijyen en büyük kalkanımız olacak."

Yeni koronavirüs düzenlemesi! 81 ile gönderildi
Gelen son dakika haberine göre, Türkiye'ye hava veya kara yoluyla giriş-çıkış yapacakların "Kovid-19 PCR" testleri, Sağlık Bakanlığı tarafından ruhsatlandırılan tüm laboratuvarlarda çalışılabilecek.
Sağlık Bakanlığı Sağlık Hizmetleri Genel Müdürlüğü tarafından 81 ilin valiliğine Kovid-19 "PCR" testi ve izolasyonu işlemlerine ilişkin yazı gönderildi. Düzenlemeyle, yurt dışı seyahati yapacak kişilere (giden/gelen), profesyonel sporcuların müsabakalar öncesi olası şüphe ve taramalarında veya mevzuatla zorunlu tutulan hallerde Kovid-19 tanısı için yapılacak PCR testleri de kamu sağlık hizmetleri fiyat tarifesinde belirlenen fiyatlar üzerinden Bakanlık tarafından ruhsatlandırılan mikrobiyoloji laboratuvar ruhsatı olan tüm kuruluşlar tarafından çalışılabilecek.
Kovid-19 PCR testi çalışan laboratuvarların dış kalite kontrol çalışmaları, Halk Sağlığı Genel Müdürlüğü tarafından yapılabilecek. Her testin sonucu, Bakanlıkça belirlenen sistem üzerine işlenecek. Test sonuçlarını bu sisteme girmeyen sağlık kuruluşları hakkında yasal işlem yapılacak. Ayrıca Bakanlık, ihtiyaç olması halinde ilgili laboratuvarların kapasitelerinin yüzde 10'unu geçmeyecek şekilde ve ücretsiz çalışılması koşuluyla test gönderebilecek.

ABD'li uzmana göre Kovid-19'un yeni mutasyonu hastalığın bulaşıcılığını artırabilir
ABD Ulusal Alerji ve Bulaşıcı Hastalıklar Enstitüsü Direktörü Dr. Anthony Fauci, yeni tip koronavirüsün (Kovid-19) mutasyona uğramış yeni bir türünün, hastalığın daha hızlı yayılmasına yol açabileceği uyarısında bulundu.
Beyaz Saray Koronavirüsle Mücadele Görev Gücünün de önde gelen üyelerinden biri olan Dr. Fauci, Amerikan Tıp Derneği yayını "The Journal of the American Medical Association" (JAMA) dergisine verdiği mülakatta, ilk olarak İtalya'da görülen yeni tür Kovid-19'un solunum sistemine tesir eden bulaşıcı etkilerinin daha fazla olduğunu belirtti.
Virüs mutasyonu hakkında "The Cell" dergisinde yayımlan araştırmaya atıf yapan Fauci, "Veriler, virüsün, (Kovid-19) daha kolay çoğalabilen, daha yoğun bulaşıcı içeriğe sahip tekil bir mutasyonunun olduğunu gösteriyor. Bu mutasyonda virüs daha kolay çoğalıp aktarılabilir hale geliyor." ifadesini kullandı.
"G614" adlı verilen türün, dünyada görülen en yaygın mutasyon olduğuna, yerel enfeksiyonların en erken ortaya çıktığı yerlerde dahi hakim haline geldiğine dikkati çeken Fauci, "Virüs türünün bir uyum avantajı olduğu anlaşılıyor, bu bulaşıcılığı artıran bir faktör olabilir." değerlendirmesinde bulundu.
Virüsün söz konusu türünün görüldüğü kişilerin üst solunum yollarında daha fazla bulaşıcı içerik tespit edildiğine, bunun kişinin hastalığı bulaştırma ihtimalini artırdığına işaret eden Fauci, türün, hastalığı daha ağır hale getirdiğine dair ise kanıt bulunmadığını kaydetti.
Peki virüsler nasıl ve neden değişime uğruyor?
Virüsler genetik seçimin bir sonucu olarak sürekli şekilde değişim geçiriyor. Hafif genetik değişimler mutasyon (değişinim) sonrası gerçekleşirken, büyük genetik değişimler rekombinasyon (yeniden birleşme) üzerine yaşanıyor.
Mutasyon virüsün genomu yani genetik materyelinde bir hata oluşması üzerine gerçekleşiyor. Rekombinasyon ise eş zamanlı enfekte olan virüslerin genetik bilgi değişimi sonrasında yeni bir tip virüs olarak ortaya çıkmasına neden oluyor.
Örneğin Covid-19 pandemisine neden olan SARS-Cov-2'nin yarasalarda bulunan bir virüsün aracı bir hayvandaki başka bir virüsle yeniden birleşmesi yani rekombinasyonu sonrasında ortaya çıktığı ve insanı etkileyebilecek genetik materyele sahip olduğu biliniyor.
Mutasyon nasıl gerçekleşiyor?
Koronavirüslerin yedinci çeşidi olan SARS-CoV-2 adını kendilerini sararak taç oluşturan protein kapsüllerinden alıyor. "Corona" Latince taç anlamına geliyor.
Bu protein kapsülleri mikroskop altında dikenlere benzeyen sivri uçlar olarak görülüyor. Bu sivri uçlar virüsün bir canlı hücresine tutunmasına yardımcı oluyor. Bunların ucundaki anahtar benzeri şekiller ise virüsün hücreye girerek çoğalmasını sağlıyor.
Kilidi açabilen yani hücre içine girmeyi başarabilen virüsler hücre içinde genetik materyelini "kopyalamaya" ve böylece hızla çoğalmaya başlıyor. Yüzlerce hatta binlerce kopyalama sırasında zaman zaman hatalar oluşuyor ve bunlar mutasyona neden oluyor.
DNA virüslerinde mutasyon oranı daha azken, RNA virüslerinde bu oran çok artıyor. Koronavirüsler RNA genomlerını kopyalayarak çoğaldıklarından yüksek oranda mutasyona uğrayabiliyor.

KORONAVİRÜS SALGINI NE ZAMAN SONA ERECEK?
Salgının sona ermesi için en az 1 yıla daha ihtiyaç olduğunu belirten Gates, aşı ve ilaç konusunda oldukça etkileyici gelişmelerin yaşandığını söyledi.
Gates, zengin ülkeler için salgının 2021 sonunda, dünyanın geri kalanı için ise 2022 sonunda biteceğini tahmin ettiğini belirtti.
ÇİN VE RUSYA'NIN AŞI ÇABALARI
Çin ve Rusya konusundaki endişelerini aktaran Gates, buradaki aşı geliştirme çabalarında çok büyük bir baskı olduğunu, düzenleyicilerin aşıların güvenli ve verimli olduğunu bilmeden insanlara verilmesine izin verebileceğini söyledi. Gates, "Sadece yan etkilerini kontrol etmek için 3. fazda muhtemelen üç ya da dört aya ihtiyacımız var" ifadelerini kullandı.
Gates geçtiğimiz aylarda verdiği bir röportajda da bilim insanlarının oldukça güvenli ve verimli bir aşı geliştireceğine inandığını söylemişti. Gates, bunun sebebi olarak ise dünya genelindeki 160'dan fazla aşı çalışmasını göstermişti.
OLDUKÇA ÇETİN GEÇECEK
Gates, ayrıca "en iyi aşının" dünyayla paylaşılmaması durumunda virüsün sürekli yeniden hortlayacağını da söyledi. Ayrıca önümüzdeki kış ve güz sezonunun da oldukça çetin geçeceğini dile getirdi.
MASKE ZORUNLULUĞU
Fransa'nın başkenti Paris'te 10 Ağustos'tan itibaren 11 yaşından büyük herkesin yoğunluğun fazla olduğu açık alanlarda maske takması zorunlu hale getirildi.
Valilik tarafından yapılan açıklamada, başkentin Seine-Saint-Denis, Hauts-de-Seine, Val-de-Marne ve le Val-d'Oise bölgelerinde 10 Ağustos'ta yerel saatle 08.00'den itibaren maske takma zorunluluğun başlayacağı duyuruldu.
Valilik, ülkedeki pozitif test sayısı ortalamasının yüzde 1,6 iken Paris'te bu ortalamanın yüzde 2,4 olması nedeni ile bu kararın alındığını aktarırken, başkentteki 20-30 yaş arası vaka sayısının diğer bölgelere göre daha fazla olduğunu bildirdi. Valilik, ayrıca Kovid-19 vaka sayılarının aralıklarla güncellenmesi ile maske takmanın zorunlu olduğu bölgelerin güncelleneceğini açıkladı.
Fransa'da toplam vaka sayısı 224 bin 638'e, can kaybı 30 bin 324'e yükseldi.
KORONAVİRÜS SON DAKİKA HABERLERİ İÇİN TIKLAYINIZ